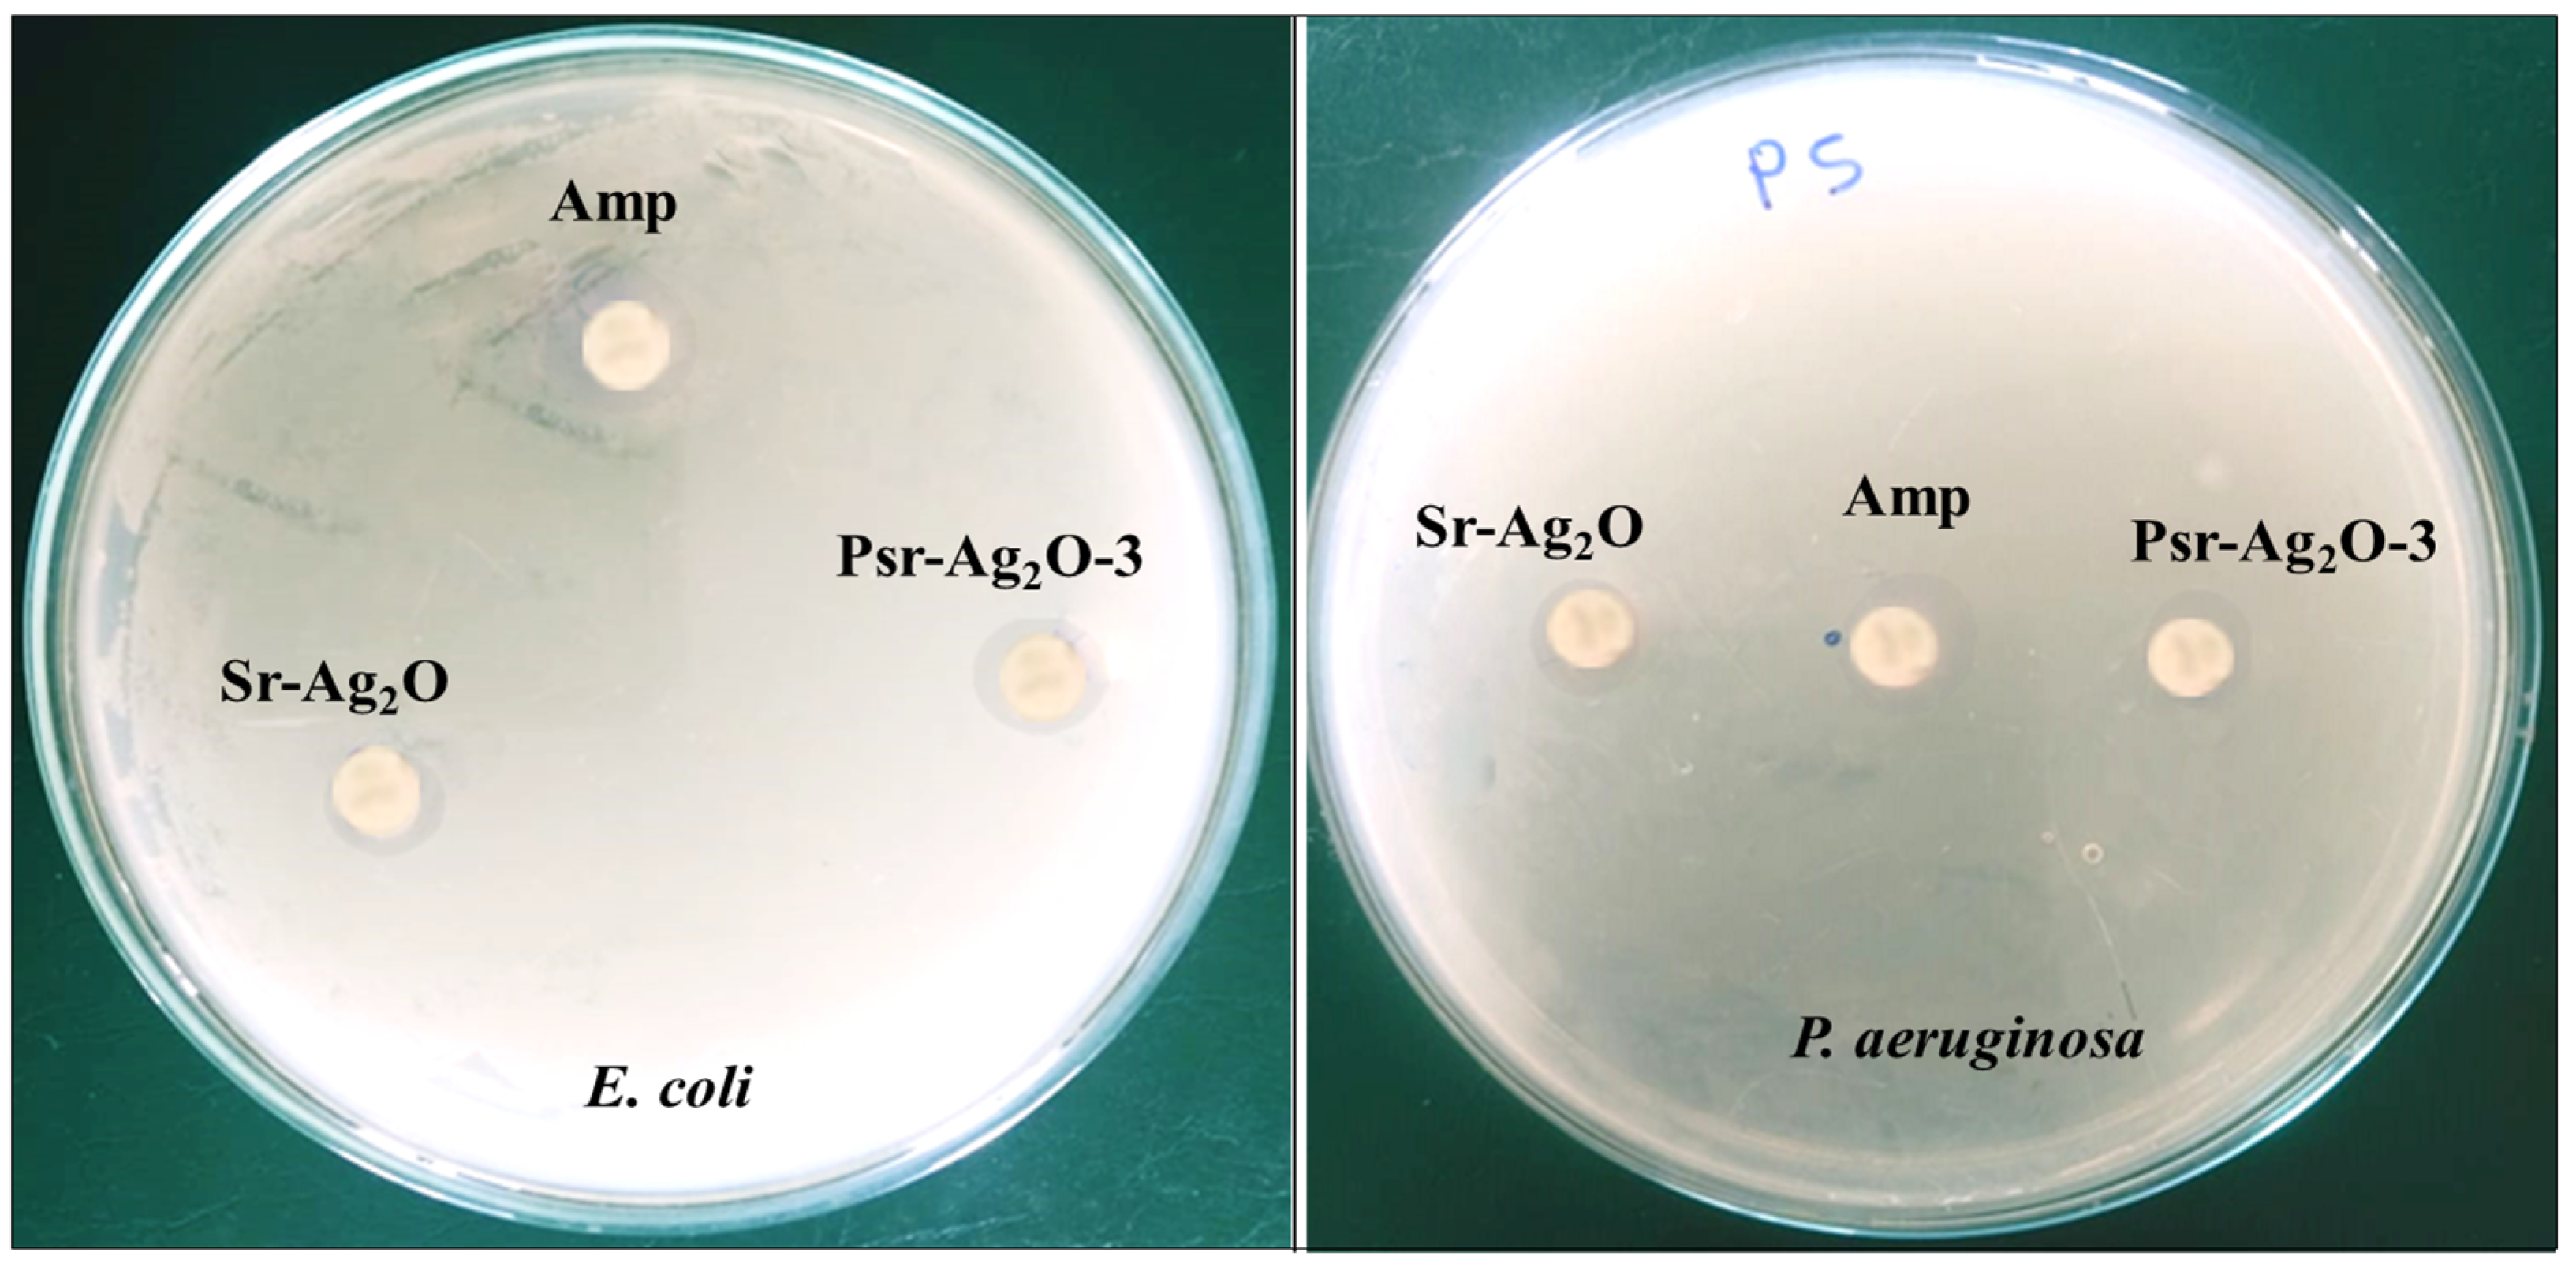

Strontium-Decorated Ag2O Nanoparticles Obtained via Green Synthesis/Polyvinyl Alcohol Films for Wound Dressing Applications
Abstract
1. Introduction
2. Materials and Methods
2.1. Materials
2.2. Synthesis of PVA
2.3. Microwave Extraction of Lablab Purpureus Peel (LPE)
2.4. Synthesis of Sr-Ag2O Nanoparticles and PVA/Sr-Ag2O (PSr-Ag2O) Nanocomposite Films
2.5. Characterizations
2.5.1. Antimicrobial Study
2.5.2. Cytotoxicity
2.5.3. Blood Compatibility (Haemolysis)
2.5.4. Cell Migration (Wound-Healing Scratch Assay)
3. Results and Discussion
3.1. UV–Visible Spectroscopy
3.2. Fourier Transform Infrared Spectroscopy (FTIR)
3.3. Mechanical Properties
3.4. Morphology
3.5. XRD Studies
3.6. Thermogravimetric Analysis
3.7. Contact Angle Analysis
3.8. Antimicrobial Study
3.9. Cytotoxicity Study
3.10. Assay Performed to Study Blood Compatibility (Haemolysis)
3.11. Cell Migration Study
4. Conclusions
Author Contributions
Funding
Institutional Review Board Statement
Informed Consent Statement
Data Availability Statement
Conflicts of Interest
References
- Thambirajoo, M.; Asma, A.N.; Busra, F.M. The insights of microbes’ roles in wound healing: A comprehensive review. Pharmaceutics 2021, 13, 981. [Google Scholar]
- Guo, S.; DiPietro, L.A. Factors affecting wound healing. J. Dent. Res. 2010, 89, 219–229. [Google Scholar] [CrossRef]
- Menon, G.K. Skin basics; structure and function. In Lipids and Skin Health; Springer: Berlin/Heidelberg, Germany, 2014; pp. 9–23. [Google Scholar]
- Hamblin, M.R. Novel pharmacotherapy for burn wounds: What are the advancements. Expert Opin. Pharmacother. 2019, 20, 305–321. [Google Scholar] [CrossRef]
- Cefalu, J.E.; Barrier, K.M.; Davis, A.H. Wound infections in critical care. Crit. Care Nurs. Clin. 2017, 29, 81–96. [Google Scholar] [CrossRef] [PubMed]
- Priscila, S.; Ulrike, A. Chronic inflammation in non-healing skin wounds and promising natural bioactive compounds treatment. Int. J. Mol. Sci. 2022, 23, 4928. [Google Scholar] [CrossRef] [PubMed]
- Lucas, S.; David, G.J. Traumatic Injuries to the Spinal Cord and Peripheral Nervous System. Emerg. Med. Clin. N. Am. 2021, 39, 1–28. [Google Scholar]
- Downie, F.; Egdell, S.; Bielby, A.; Searle, R. Barrier dressings in surgical site infection prevention strategies. Br J. Nurs. 2010, 19, S42–S46. [Google Scholar] [CrossRef]
- Negut, I.; Grumezescu, V.; Grumezescu, A.M. Treatment strategies for infected wounds. Molecules 2018, 23, 2392. [Google Scholar] [CrossRef]
- Simoes, D.; Miguel, S.P.; Ribeiro, M.P.; Coutinho, P.; Mendonça, A.G.; Correia, I.J. Recent advances on antimicrobial wound dressing: A review. Eur. J. Pharm. Biopharm. 2018, 127, 130–141. [Google Scholar] [CrossRef]
- Zhang, X.; Wang, Y.; Gao, Z.; Mao, X.; Cheng, J.; Huang, L.; Tang, J. Advances in wound dressing based on electrospinning nanofibers. J. Appl. Polym. Sci. 2024, 141, 54746. [Google Scholar] [CrossRef]
- Nagaraj, N.; Duncan, H.; Gregory, T.M. Energy-saving pathways for thermoelectric nanomaterial synthesis: Hydrothermal/solvothermal, microwave-assisted, solution-based, and powder processing. Adv. Sci. 2022, 9, 2106052. [Google Scholar]
- Suresh, G.; Shreyas, P.; Muhammad, B.; Shirish, S.P.; Rajeshwari, O. Environmentally friendly synthesis of Cr2O3 nanoparticles: Characterization, applications and future perspective a review. Case Stud. Chem. Environ. Eng. 2021, 3, 100089. [Google Scholar]
- Chetan, P.; Arpita, R.; Suresh, G.; Ameer, K.; Mohammad, N.I.; Talha, B.E.; Siok, E.L.; Mayeen, U.K.; David, A.B. Biological agents for synthesis of nanoparticles and their applications. J. King Saud Univ. Sci. 2022, 34, 101869. [Google Scholar]
- Sharma, N.; Allardyce, B.J.; Rajkhowa, R.; Agrawal, R. Delivery of agrochemicals and nutrients through a biopolymer-based system derived from lignocellulosic rice straw. J. Polym. Environ. 2023, 31, 4606–4620. [Google Scholar] [CrossRef]
- Sharma, N.; Allardyce, B.J.; Rajkhowa, R.; Agrawal, R. Rice straw-derived cellulose: A comparative study of various pre-treatment technologies and its conversion to nanofibers. Sci. Rep. 2023, 13, 16327. [Google Scholar] [CrossRef]
- Sharma, N.; Allardyce, B.J.; Rajkhowa, R.; Agrawal, R. Agrawal, Biodegradation of N-fertilizer loaded on cellulose nanofibres to assess their potential use as a controlled-release fertilizer. J. Mater. Sci. 2023, 58, 17859–17872. [Google Scholar] [CrossRef]
- Kaur, P.; Singh, S.; Sharma, N.; Agrawal, R. Filling in the gaps in second-generation biorefineries: Evaluating rice straw and its bioethanol residue for the production of biogenic silica nanoparticles. Nanotechnol. Environ. Eng. 2024, 9, 67–76. [Google Scholar] [CrossRef]
- Sharma, N.; Allardyce, B.J.; Rajkhowa, R.; Agrawal, R. Controlled release fertilizer delivery system derived from rice straw cellulose nanofibres: A circular economy based solution for sustainable development. Bioengineered 2023, 14, 2242124. [Google Scholar] [CrossRef]
- Paul, A.; Roychoudhury, A. Go green to protect plants: Repurposing the antimicrobial activity of biosynthesized silver nanoparticles to combat phytopathogens. Nanotech. Envi. Eng. 2021, 6, 10. [Google Scholar] [CrossRef]
- Narasimharao, B.; Naga, V.K.A.; Ramesh, B.; Pradeep Kumar, M.; Reddy, O.V.S.; Venugopal, G.; Raj Kumar, K.; Praveen, K.P.; Venkataraman, B. Anti-Inflammatory and Anti-DiabeticActivities with Their Other Ethnomedicinal Properties of the Plants. J. Med. Plants Stud. 2013, 1, 87–96. [Google Scholar]
- Deoda, R.S.; Pandya, H.; Patel, M.; Yadav, K.N.; Kadam, P.V.; Patil, M.J. Antilithiatic activity of leaves, bulb and stem of Nymphea odorata and Dolichos lablab Beans. Res. J. Pharmaceut. Biolog. Chem. Sci. 2012, 3, 814–819. [Google Scholar]
- Torres, R.C.; Manalo, J.B. Phyto-chemical investigation of Dolichos lablab L. by thin layer chromatography. Philipp. Tech. J. 1990, 15, 41–50. [Google Scholar]
- Balekari, U. Antihyperglycemic and antihyperlipidaemic activities of dolichos lablab seed extract on streptozotocin—Nicotinamide induced diabetic rats. In Proceedings of the International Conference and Exhibition on Pharmacognosy, Phytochemistry and Natural Poroducts, Hyderabad, India, 21–23 October 2013; pp. 21–23. [Google Scholar]
- Gholamali, I.; Asnaashariisfahani, M.; Alipour, E. Silver nanoparticles incorporated in pH-sensitive nanocomposite hydrogels based on carboxymethyl chitosan-poly (vinyl alcohol) for use in a drug delivery system. Regen. Eng. Transl. Med. 2020, 6, 138–153. [Google Scholar] [CrossRef]
- Kadhim, W.K.A.; Nayef, U.M.; Jabir, M.S. Polyethylene glycol-functionalized magnetic (Fe3O4) nanoparticles: A good method for a successful antibacterial therapeutic agent via damage DNA molecule. Surf. Rev. Lett. 2019, 26, 1950079. [Google Scholar] [CrossRef]
- Kalantari, K.; Mostafavi, E.; Saleh, B.; Soltantabar, P.; Webster, T.J. Chitosan/PVA hydrogels incorporated with green synthesized cerium oxide nanoparticles for wound healing applications. Eur. Polym. J. 2020, 134, 109853. [Google Scholar] [CrossRef]
- Abdollahi, Z.; Zare, E.N.; Salimi, F.; Goudarzi, I.; Tay, F.R.; Makvandi, P. Bioactive carboxymethyl starch-based hydrogels decorated with CuO nanoparticles: Antioxidant and antimicrobial properties and accelerated wound healing in vivo. Int. J. Mol. Sci. 2021, 22, 2531. [Google Scholar] [CrossRef] [PubMed]
- Baker, M.I.; Walsh, S.P.; Schwartz, Z.; Boyan, B.D. A review of polyvinyl alcohol and its uses in cartilage and orthopedic applications. J. Biomed. Mater. Res. B Appl. Biomater. 2012, 100, 1451–1457. [Google Scholar] [CrossRef]
- Gaaz, T.; Sulong, A.; Akhtar, M.; Kadhum, A.; Mohamad, A.; Al-Amiery, A. Properties and applications of polyvinyl alcohol, halloysite nanotubes and their nanocomposites. Molecules 2015, 20, 22833–22847. [Google Scholar] [CrossRef]
- Massarelli, E.; Silva, D.; Pimenta, A.F.R.; Fernandes, A.I.; Mata, J.L.G.; Armês, H.; Salema-Oom, M.; Saramago, B.; Serro, A.P. Polyvinyl Alcohol/Chitosan Wound Dressings Loaded with Antiseptics. Int. J. Pharm. 2021, 593, 120110. [Google Scholar] [CrossRef]
- Elumalai, A. Using strontium coated clay nanoparticles for bone regeneration and other biomedical applications. Ph.D. Thesis, Louisiana Tech University, Ruston, LA, USA, 2020; p. 847. [Google Scholar]
- Hekimoglu, A.P.; Çalıs, M.A.G. Effect of strontium and magnesium additions on the microstructure and mechanical properties of Al–12Si alloys. Met Mater. Int. 2019, 25, 1488–1499. [Google Scholar] [CrossRef]
- Anbu, P.; Gopinath, S.C.; Salimi, M.N.; Letchumanan, I.; Subramaniam, S. Green synthesized strontium oxide nanoparticles by Elodea canadensis extract and their antibacterial activity. J. Nanostructure Chem. 2022, 12, 1–9. [Google Scholar] [CrossRef]
- Sinha, P.; Boopathi, P.; Suresh, V.; Pitchiah, S. Anti-inflammatory properties of strontium oxide nanoparticles synthesized from suaeda monoica saltmarsh. Cureus 2024, 16, 56355. [Google Scholar] [CrossRef]
- Joy, A.; Unnikrishnan, G.; Megha, M.; Haris, M.; Thomas, J.; Kolanthai, E.; Muthuswamy, S. Design of biocompatible polycaprolactone-based nanocomposite loaded with graphene oxide/strontium nanohybrid for biomedical applications. Appl. Nanosci. 2023, 13, 4471–4484. [Google Scholar] [CrossRef]
- Kasirajan, K.; Karunakaran, M. Synthesis and characterization of strontium cerium mixed oxide nanoparticles using plant extract. Sens. Lett. 2019, 17, 924–937. [Google Scholar] [CrossRef]
- ASTM D882-91; Tensile properties (sheet). Tensile testing of thin plastic sheeting (film). ASTM International: West Conshohocken, PA, USA, 2009.
- Kasthuri, A.; Pandian, P. Eco-friendly synthesis of strontium oxide nanoparticles using solanum nigrum leaf extract: Characterization and antibacterial potential. Orient. J. Chem. 2023, 39, 1344–1350. [Google Scholar] [CrossRef]
- Ayinde, W.B.; Gitari, W.M.; Samie, A. Optimization of microwave-assisted synthesis of silver nanoparticle by Citrus paradisi peel and its application against pathogenic water strain. Green Chem. Lett. Rev. 2019, 12, 225–234. [Google Scholar] [CrossRef]
- Jyoti, K.; Baunthiyal, M.; Singh, A. Characterization of silver nanoparticles synthesized using Urtica dioica Linn. leaves and their synergistic effects with antibiotics. J. Radiat. Res. Appl. Sci. 2016, 9, 217–227. [Google Scholar] [CrossRef]
- Hendrawan, H.; Khoerunnisa, F.; Sonjaya, Y.; Putri, A.D. Poly (vinyl alcohol)/glutaraldehyde/Premna oblongifolia merr extract hydrogel for controlled-release and water absorption application. IOP Conf. Ser. Mater. Sci. Eng. 2019, 509, 012048. [Google Scholar] [CrossRef]
- Al-Kadhemy, M.F.H.; Ibrahim, S.A.; Salman, J.A.S. Studying the physical properties polyvinyl alcohol polymer mixture with silica nanoparticles and its application as pathogenic bacteria inhibitor. AIP Conf. Proc. 2020, 2290, 050013. [Google Scholar] [CrossRef]
- Gungure, A.S.; Jule, L.T.; Nagaprasad, N.; Ramaswamy, K. Studying the properties of green synthesized silver oxide nanoparticles in the application of organic dye degradation under visible light. Sci. Rep. 2024, 14, 26967. [Google Scholar] [CrossRef]
- Gungure, A.S.; Jule, L.T.; Ramaswamy, K.; Nagaprasad, N.; Ramaswamy, S. Photo and electrochemical applications of green synthesized ZnO/Ag2O nanocomposites materials under visible light using P. macrosolen L. leaf. Sci. Rep. 2025, 15, 7234. [Google Scholar] [CrossRef] [PubMed]
- Peles, Z.; Zilberman, M. Novel Soy Protein Wound Dressings with Controlled Antibiotic Release: Mechanical and Physical Properties. Acta Biomater. 2012, 8, 209–217. [Google Scholar] [CrossRef]
- Korbag, I.; Mohamed, S.S. Studies on mechanical and biodegradability properties of PVA/lignin blend films. Int. J. Environ. Stud. 2016, 73, 18–24. [Google Scholar] [CrossRef]
- Naqvi, S.M.K.; Khan, Z.; Mirza, E.H.; Chandio, A.; Manzoor, F.; Niaz, R.; Khan, A.A.; Al Khureif, A.A. Fabrication and characterization of polyvinyl alcohol/chitosan/moringa-extract hydrogel patch for wound-healing applications. Mater. Expr. 2021, 11, 107–115. [Google Scholar] [CrossRef]
- Ibrahim, H.M.; Zaghloul, S.; Hashem, M.; El-Shafei, A. A green approach to improve the antibacterial properties of cellulose based fabrics using moringa oleifera extract in presence of silver nanoparticles. Cellulose 2021, 28, 549–564. [Google Scholar] [CrossRef]
- Zhao, Y.; Li, Z.; Song, S.; Yang, K.; Liu, H.; Yang, Z.; Wang, J.; Yang, B.; Lin, Q. Skin-inspired antibacterial conductive hydrogels for epidermal sensors and diabetic foot wound dressings. Adv. Funct. Mater. 2019, 29, 1901474. [Google Scholar] [CrossRef]
- Xie, Y.; Cai, P.; Cao, X.; Chen, B.; Pan, Y. Water-Resistant Poly (vinyl alcohol)/ZnO Nanopillar Composite Films for Antibacterial Packaging. ACS Omega 2024, 9, 50403–50413. [Google Scholar] [CrossRef]
- Srivastava, N.; Choudhary, M.; Singhal, G.; Bhagyawant, S.S. SEM studies of saponin silver nanoparticles isolated from leaves of Chenopodium album L. for in vitro anti-acne activity. Proc. Natl. Acad. Sci. India Sect. B Biol. Sci. 2020, 90, 333–341. [Google Scholar] [CrossRef]
- Sivaiah, K.; Hemalatha, B.; Buddhudu, S. Structural, thermal and optical properties of Cu2+ and Co2+: PVP polymer films. J. Pure Appl. Phys. 2010, 48, 658–662. [Google Scholar]
- Menazea, A.A.; Ismail, A.M.; Awwad, N.S.; Ibrahium, H.A. Physical characterization and antibacterial activity of PVA/Chitosan matrix doped by selenium nanoparticles prepared via onepot laser ablation route. J. Mater. Res. Tech. 2020, 9, 9598–9606. [Google Scholar] [CrossRef]
- Shrishail, P.; Vanita, G.; Sharanappa, C.; Vidya, G.; Yogesh, K.K.; Raghu, M.S.; Vidyavathi, G.T.; Nagaraj, N.; Deepak, R.K. Poly(vinyl alcohol) nanocomposites reinforced with CuO nanoparticles extracted by Ocimum sanctum: Evaluation of wound-healing applications. Polymers 2025, 17, 400. [Google Scholar]
- Hasheminya, S.M.; Mokarram, R.R.; Ghanbarzadeh, B.; Hamishekar, H.; Kafil, H.S. Physicochemical, mechanical, optical, microstructural and antimicrobial properties of novel kefiran-carboxymethyl cellulose biocomposite films as influenced by copper oxide nanoparticles (CuONPs). Food Packag. Shelf-Life 2018, 17, 196–204. [Google Scholar] [CrossRef]
- Prasad, S.K.; Bhat, S.S.; Shivamallu, C.; Prasad, K.S. Biomedical Importance of Lablab purpureus: A Review. Med. Plants 2022, 14, 20–29. [Google Scholar] [CrossRef]
- Thoyajakshi, R.S.; Poornima, D. Anticoagulant, Fibrinogenolytic and Anti-Platelet Aggregation Activities of Lablab purpureus (L.) Sweet Seed Radicle Aqueous Extract. Plant Sci. Today 2021, 8, 89–94. [Google Scholar] [CrossRef]
- MTT Cell Proliferation Assay Instruction Guide—ATCC, VA, USA. Available online: www.atcc.org (accessed on 17 July 2025).
- Gerlier, D.; Thomasset, N. Use of MTT colorimetric assay to measure cell activation. J. Immunol. Method. 1986, 94, 57–63. [Google Scholar] [CrossRef] [PubMed]
- Mosmann, T. Rapid colorimetric assay for cellular growth and survival: Application to proliferation and cytotoxicity assays. J. Immunol. Method 1983, 65, 55–63. [Google Scholar] [CrossRef]
- Alley, M.C.; Scudiere, D.A.; Monks, A.; Czerwinski, M.; Shoemaker, R.; Boyd, M.R. Validation of an automated microculture tetrazolium assay (MTA) to assess growth and drug sensitivity of human tumor cell lines. Proc. Am. Assoc. Cancer Res. 1986, 27, 389. [Google Scholar]
- Karla, B.R.; Imelda, O.A.; Christian, C.G.; Vera, A.A.; Perla, E.G.C. Cytotoxic effect of polyvinyl alcohol-magnetite composite. SN App. Sci. 2023, 5, 254. [Google Scholar]
- Manikandan, A.; Mohan, P.M.; Saravana, K.J.; Rajashekar, R. Preparation, characterization and blood compatibility assessment of a novel electrospun nanocomposite comprising polyurethane and ayurvedic-indhulekha oil for tissue engineering applications. Biomed. Eng. Biomedizinische Technik. 2025, 63, 1–9. [Google Scholar]
- Sovadinova, I.; Palermo, E.F.; Huang, R.; Thoma, L.M.; Kuroda, K. Mechanism of polymer-induced hemolysis: Nanosized pore formation and osmotic lysis. Biomacromolecules 2011, 12, 260–268. [Google Scholar] [CrossRef]
- Phuong, P.T.; Oliver, S.; He, J.; Wong, E.H.; Mathers, R.T.; Boyer, C. Effect of hydrophobic groups on antimicrobial and hemolytic activity: Developing a predictive tool for ternary antimicrobial polymers. Biomacromolecules 2020, 21, 5241–5255. [Google Scholar] [CrossRef] [PubMed]
- Liu, S.; Hu, M.; Zeng, T.H.; Wu, R.; Jiang, R.; Wei, J.; Wang, L.; Kong, J.; Chen, Y. Lateral dimension-dependent antibacterial activity of graphene oxide sheets. Langmuir 2012, 28, 12364–12372. [Google Scholar] [CrossRef] [PubMed]
- Nair, L.S.; Laurencin, C.T. Biodegradable Polymers as Biomaterials. Prog. Polym. Sci. 2007, 32, 762–798. [Google Scholar] [CrossRef]

| Sample Name | Thickness (mm) | PVA (g) | Sr-Ag2O (g) |
|---|---|---|---|
| PVA | 0.09 | 2 | 0 |
| PSr-Ag2O-1 | 0.08 | 1.98 | 0.02 |
| PSr-Ag2O-2 | 0.07 | 1.96 | 0.04 |
| PSr-Ag2O-3 | 0.09 | 1.94 | 0.06 |
| Sample Name | Tensile Strength (Ts) | Young’s Modulus (Ym) | % Elongation at Break (Eb) |
|---|---|---|---|
| PVA | 27.98 ± 1.2 | 979.27 ± 20 | 394.32 ± 5.1 |
| PSr-Ag2O-1 | 37.40 ± 1.5 | 970.69 ± 25 | 99.21 ± 4.8 |
| PSr-Ag2O-2 | 36.76 ± 1.3 | 1204.06 ± 18 | 74.17 ± 6.0 |
| PSr-Ag2O-3 | 31.88 ± 1.4 | 1093.98 ± 22 | 69.65 ± 4.5 |
| Film Sample | Contact Angle (°) |
|---|---|
| PVA | 65.37 ± 2.2 |
| PSr-Ag2O-1 | 78.46 ± 1.7 |
| PSr-Ag2O-3 | 88.29 ± 2.3 |
| SampleName | Inhibition Zone (Diameter of Growth in mm) | |
|---|---|---|
| E. coli | P. aeruginosa | |
| Sr-Ag2O | 11.3 ± 0.4 | 8.7 ± 0.7 |
| PSr-Ag2O-3 | 12.7 ± 0.8 | 11.8 ± 0.5 |
| Ampicillin | 20.2 ± 0.6 | 21.3 ± 0.6 |
| Sample Name | L929 Cell Line IC50 (in µg/mL) 24 h | Haemolysis (%) |
|---|---|---|
| Sr-Ag2O | 55.44 | 38.56 ± 0.0775 |
| PSr-Ag2O-3 | 63.53 | 44.75 ± 0.0052 |
| Sample Name | Duration (h) | Cell Migration (µm) | % of Wound Closure (24 h) |
|---|---|---|---|
| Sr-Ag2O (15 µg) | 12 | 22.48 | 30.82 |
| 24 | 17.49 | ||
| PSr-Ag2O-3 (15 µg) | 12 | 19.95 | 32.87 |
| 24 | 7.70 |
Disclaimer/Publisher’s Note: The statements, opinions and data contained in all publications are solely those of the individual author(s) and contributor(s) and not of MDPI and/or the editor(s). MDPI and/or the editor(s) disclaim responsibility for any injury to people or property resulting from any ideas, methods, instructions or products referred to in the content. |
© 2025 by the authors. Licensee MDPI, Basel, Switzerland. This article is an open access article distributed under the terms and conditions of the Creative Commons Attribution (CC BY) license (https://creativecommons.org/licenses/by/4.0/).
Share and Cite
Ghatti, V.; Chapi, S.; Kumar Kumarswamy, Y.; Nandihalli, N.; Kasai, D.R. Strontium-Decorated Ag2O Nanoparticles Obtained via Green Synthesis/Polyvinyl Alcohol Films for Wound Dressing Applications. Materials 2025, 18, 3568. https://doi.org/10.3390/ma18153568
Ghatti V, Chapi S, Kumar Kumarswamy Y, Nandihalli N, Kasai DR. Strontium-Decorated Ag2O Nanoparticles Obtained via Green Synthesis/Polyvinyl Alcohol Films for Wound Dressing Applications. Materials. 2025; 18(15):3568. https://doi.org/10.3390/ma18153568
Chicago/Turabian StyleGhatti, Vanita, Sharanappa Chapi, Yogesh Kumar Kumarswamy, Nagaraj Nandihalli, and Deepak R. Kasai. 2025. "Strontium-Decorated Ag2O Nanoparticles Obtained via Green Synthesis/Polyvinyl Alcohol Films for Wound Dressing Applications" Materials 18, no. 15: 3568. https://doi.org/10.3390/ma18153568
APA StyleGhatti, V., Chapi, S., Kumar Kumarswamy, Y., Nandihalli, N., & Kasai, D. R. (2025). Strontium-Decorated Ag2O Nanoparticles Obtained via Green Synthesis/Polyvinyl Alcohol Films for Wound Dressing Applications. Materials, 18(15), 3568. https://doi.org/10.3390/ma18153568







